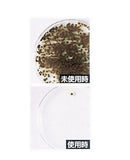
天然乳酸防霉除菌清潔噴霧 500ml(乳酸クリーナー  カビグッバイ 500ml)【含運費】

天然乳酸防霉除菌清潔噴霧 500ml(乳酸クリーナー カビグッバイ 500ml)【含運費】
為配合國際物流運送規則,結帳時請將您的住址以英文輸入,感謝您的配合!
●不添加漂白劑、不含氯,沒有刺鼻的異味,不含漂白成分,不小心沾到衣物上,也不用擔心會脫色
●無添加鹽酸,僅用乳酸的力量就能夠去除黴菌,是一款對人體沒有傷害的清潔劑。因為幾乎沒有對人體的影響,使用時也不必使用手套、眼鏡或口罩等等的防護用具
●採用天然乳酸製成,即使在門窗緊閉的浴室內,也不會有難聞的氣味產生
●使用範圍廣,另可清潔除菌廚房水槽排水孔,也可以使用在櫥櫃等木質產品上,殺死黑黴菌效果高達98%以上,噴灑約5-10分鐘後,利用刷子或是棉布沖水清洗即可
カビグッバイは塩素を使わず乳酸パワーでカビを落とす、人体に優しいクリーナーです。人体への影響がほとんどない為、手袋・眼鏡・マスク等は必要ありません。入浴中や戸・窓を閉めたままでも嫌な臭いを気にせず使えます。天然の乳酸でカビを落とします。
漂白作用が無い為、衣服に付いても大丈夫で、キャビネットや押入れ等の木部にも使えます。お風呂の床・壁のカビを落とすだけでなく、浴槽内側や洗面台の湯垢取り、キッチンのシンク・排水口のヌメリ取り等色々な場所の除菌・クリーナーとして活用できます。
【商品尺寸】
W9×D7.5×H20.5(有安裝噴嘴時)
重量:580g
【商品材質】
發酵乳酸・奎寧酸・奎寧酸鈉・界面活性劑(聚氧乙烯烷基醚)・香料・水
液體:弱酸性